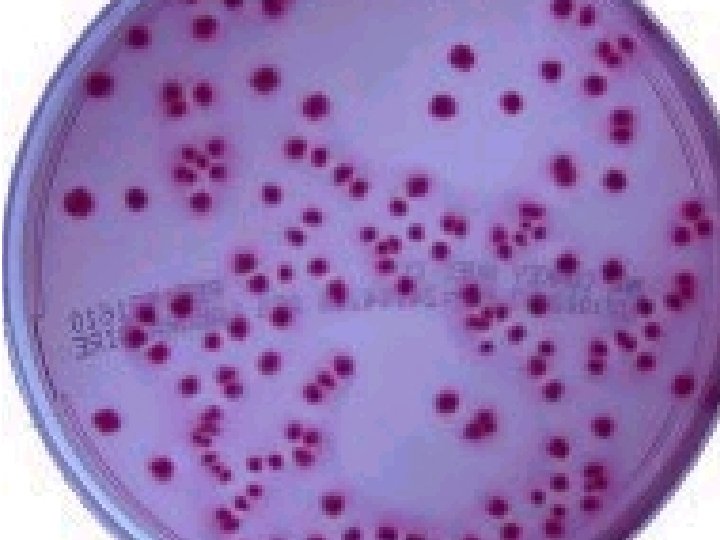
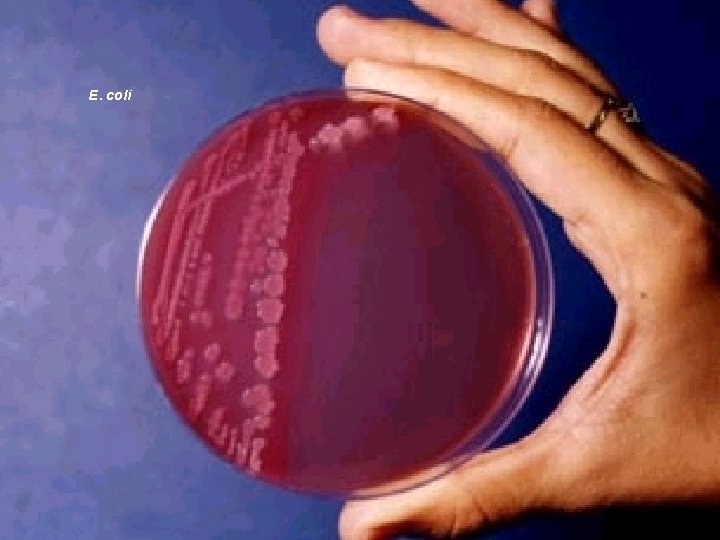
E. coli

Identificao de Enterobactrias Dra Tnia Mara Ibelli Vaz

Identificação de Enterobactérias. Dra. Tânia Mara Ibelli Vaz Pesquisador Científico Instituto Adolfo Lutz - São Paulo

Família Enterobacteriaceae Patogenia Isolamento e identificação de enterobactérias Aspecto das colônias Identificação Bioquímica ( cultura pura) Reação de VM e VP Escherichia coli Salmonella Shigella Klebsiella Enterobacter Serratia Citrobacter Proteus - Providencia - Morganella Fluxograma BGN OXIDASE Considerações finais índice

Família Enterobacteriaceae Introdução Definição • • • Bacilos Gram negativos AAF / Fermentadores da glicose Oxidase negativa e catalase + Móveis / imóveis Cresce em meios comuns Habitat Plantas, solo, água, intestino do homem e animais

Família Enterobacteriaceae Introdução Nomenclatura e Classificação • • Métodos Fenotípicos Moleculares novas espécies reclassificação Classificação • Gêneros ( 42) • Espécies ( centenas ) • biotipos e sorotipos Complexos

Identificação de Enterobactérias Classificação - patogenia - Enteropatógenos - Infecções nosocomiais - espécies importantes - Outras espécies - raras em material clínico isoladas em : meio ambiente plantas animais

Família Enterobacteriaceae Patogenia Enterobactérias - principal componente da flora intestinal normal do homem. • Infecções -intestinal, feridas e trato urinário • Abcessos, pneumonia, meningites • Infecções nosocomiais

Família Enterobacteriaceae Patogenia Infecções intestinais Características • normalmente na comunidade • DTA – doença transmitida por alimento • surtos / casos isolados • hospitalar Patógenos entéricos clássicos Salmonella spp Shigella spp E. coli - categorias diarreiogênicas Yersinia enterocolitica

Família Enterobacteriaceae Patogenia Infecções extra-intestinais Comunidade Hospitalar • Qualquer espécie • Fatores de risco: Paciente Veículos de transmissão Alimentos contaminados Espécies mais comuns Escherichia coli Klebsiella pneumoniae Klebsiella oxytoca Proteus mirabilis Enterobacter spp Salmonella ( sorotipos) Serratia marcescens Citrobacter spp Providencia spp

Família Enterobacteriaceae ISOLAMENTO E IDENTIFICAÇÃO DE ENTEROBACTÉRIAS Crescem bem nos meios comuns e meios seletivos para BGN ( 18 a 24 h 1 mm de diâmetro). 1 - Exame macroscópico da cultura: • Aspecto morfológico das colônias ( AS, MC, SS, TSA ) • Tempo de crescimento e tamanho da colônia • Observar pureza da cultura 2 -Exame microscópico da cultura: • Gram: tamanho, morfologia, reação tintorial, etc

Aspecto das colônias Agar Mac. Conkey

Aspecto das colônias Salmonella. E. coli E. cloacae

Salmonella.
E. coli

E. cloacae Aspecto das colônias

Família Enterobacteriaceae Identificação Bioquímica ( cultura pura) Meios presuntivos • IAL (Pessoa e Silva) • EPM-MILI • TSI IAL

Família Enterobacteriaceae Identificação Bioquímica Série completa - 47 testes Provas complementares: Fermentação de açúcares LDC- ODC - ADH Ci. Si Pesquisa de enzimas DNase gelatinase, lipase, NAR, ONPGase Gram Oxidase VM e VP

Família Enterobacteriaceae Reação de VM e VP Enterobactérias VP+ Enterobactérias VP - • • • Maioria das espécies dos outros Gêneros • Salmonella • Shigella • E. coli • Proteus • Morganella • Providencia • Citrobacter • Kluyvera Enterobacter Klebsiella Serratia

Escherichia coli Diagnóstico Diferencial lac+ CISI - K. oxytoca ( LDC+/ motil. -Ci. Si+) Citrato de Simmons Prova Citrobacter amalonaticus e C. diversus ( LDC-/motil. +Ci. Si+) Marcadores Epidemiológicos Infec. Intestinais Sorotipagem Fatores de virulência Infec. Extra-intestinais Sorotipagem Met. moleculares Glicose+/Gás+/sacarose+/urease*H 2 STDAindol+ LDC+/Motilidade+/- Aeromonas

Salmonella Diagnóstico diferencial Citrobacter spp ( H 2 S + ) Proteus Prova de Fermentação glicerol Marcadores Sorotipagem Fagotipagem Moleculares Glicose+/gás v sac H 2 S + urease. TDA indol LDC + Mov. + Ci. Si+ Lac -

Shigella Diagnóstico diferencial E. coli ( LDC - / Mov. -) Lactose Ci Christ. Acetato Trab. Citrato Sódio Marcadores Sorotipagem Met. moleculares Glic. + /gás sac urease TDA H 2 S indol v LDC Mov. - Ci. Si Lac -

Klebsiella Diagnóstico diferencial Enterobacter ( LDC+ / Mov. -) ADH ODC Fermentação Marcadores Sorotipagem Met. moleculares Lac+ Ci. Si +

Enterobacter Diagnóstico diferencial Enterobacter Klebsiella Serratia LDC, ODC, ADH Motilidade DNase Fermentação E. cloacae Marcadores Sorotipagem Met. moleculares Lac+ Ci. Si+

Serratia Espécies de Serratia LDC, ODC, malonato, fermentação , pigmento Marcadores: Sorotipagem Met. moleculares Glic. + / gássac. urease H 2 S TDA indol LDC + Mov. + DNase + Gelatinase + Lipase + Ci. Si + Lac -

Citrobacter Espécies de Citrobacter ODC, indol, H 2 S malonato fermentação Glic. + / gássac =V Ci. Si + urease Lac + H 2 S = V TDA indol = V LDC Mov. +

Proteus - Providencia - Morganella Diagnóstico diferencial Proteus Providencia Espécies H 2 S + BGN NF Swarming TDA, H 2 S, ODC, gelatinase, fermentação Glic. +/ gás sac. urease + TDA + H 2 S = V indol = V LDC Mov. + Ci. Si + Lac +

Fluxograma BGN Oxidase Lac + Lac - Ágar Mac Conkey IAL E. coli Enterobacter Klebsiella Kluyvera Citrobacter Shigella Salmonella Serratia Proteus Providencia Morganella + Enterobacter Klebsiella Kluyvera Citrobacter VP + Salmonella Serratia Proteus/Prov. (V) + Cit. Simmons - E. coli Shigella Morganella -

IDENTIFICAÇÃO DE ENTEROBACTÉRIAS Enterobactérias em microbiologia clínica Poucas espécies Espécies incomuns , novas espécies, espécies atípicas podem ocorrer (isoladas de material clínico, ambiente, plantas e animais) PROBABILIDADES • • • Tratar-se de uma espécie rara Cepa contaminada Uma ou mais testes não adequados na identificação ( turvação) Manipulação errada ( concentração do inóculo) Composição e quantidade do meio ( substrato presente) Controle de Q

IDENTIFICAÇÃO DE ENTEROBACTÉRIAS O que fazer? Checar tudo: • Pureza da cultura • Repetir todos os testes no mesmo sistema ou utilizando meios anteriormente utilizados • Repetir todos os testes em outro sistema de utilizar partidas diferentes do meio. • Encaminhar para laboratórios de referência os identificação ou

Considerações finais Importância da caracterização das espécies • Evitar falsos surtos • Não identificação do surto • Atenção para cepas atípicas • Atenção para espécies raras • Atenção para pureza das culturas
- Slides: 31